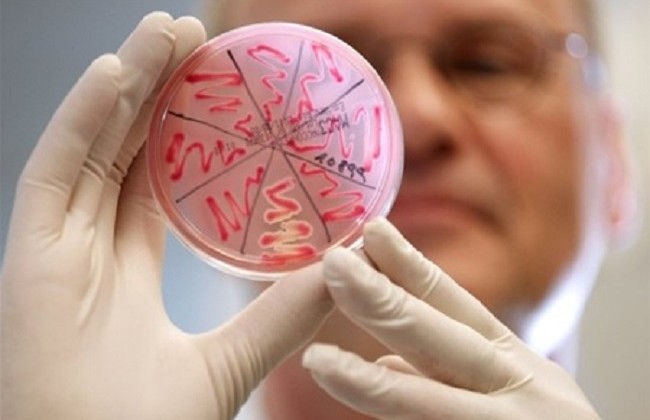

В Запорожье выросла заболеваемость острыми кишечными инфекциями
Заболеваемость острыми кишечными инфекциями в Запорожье выросла на 9,4%, зарегистрировано 93 случая. Заболеваемость среди детей до 1 года выросла в 2,4 раза: зарегистрировано 22 случая …